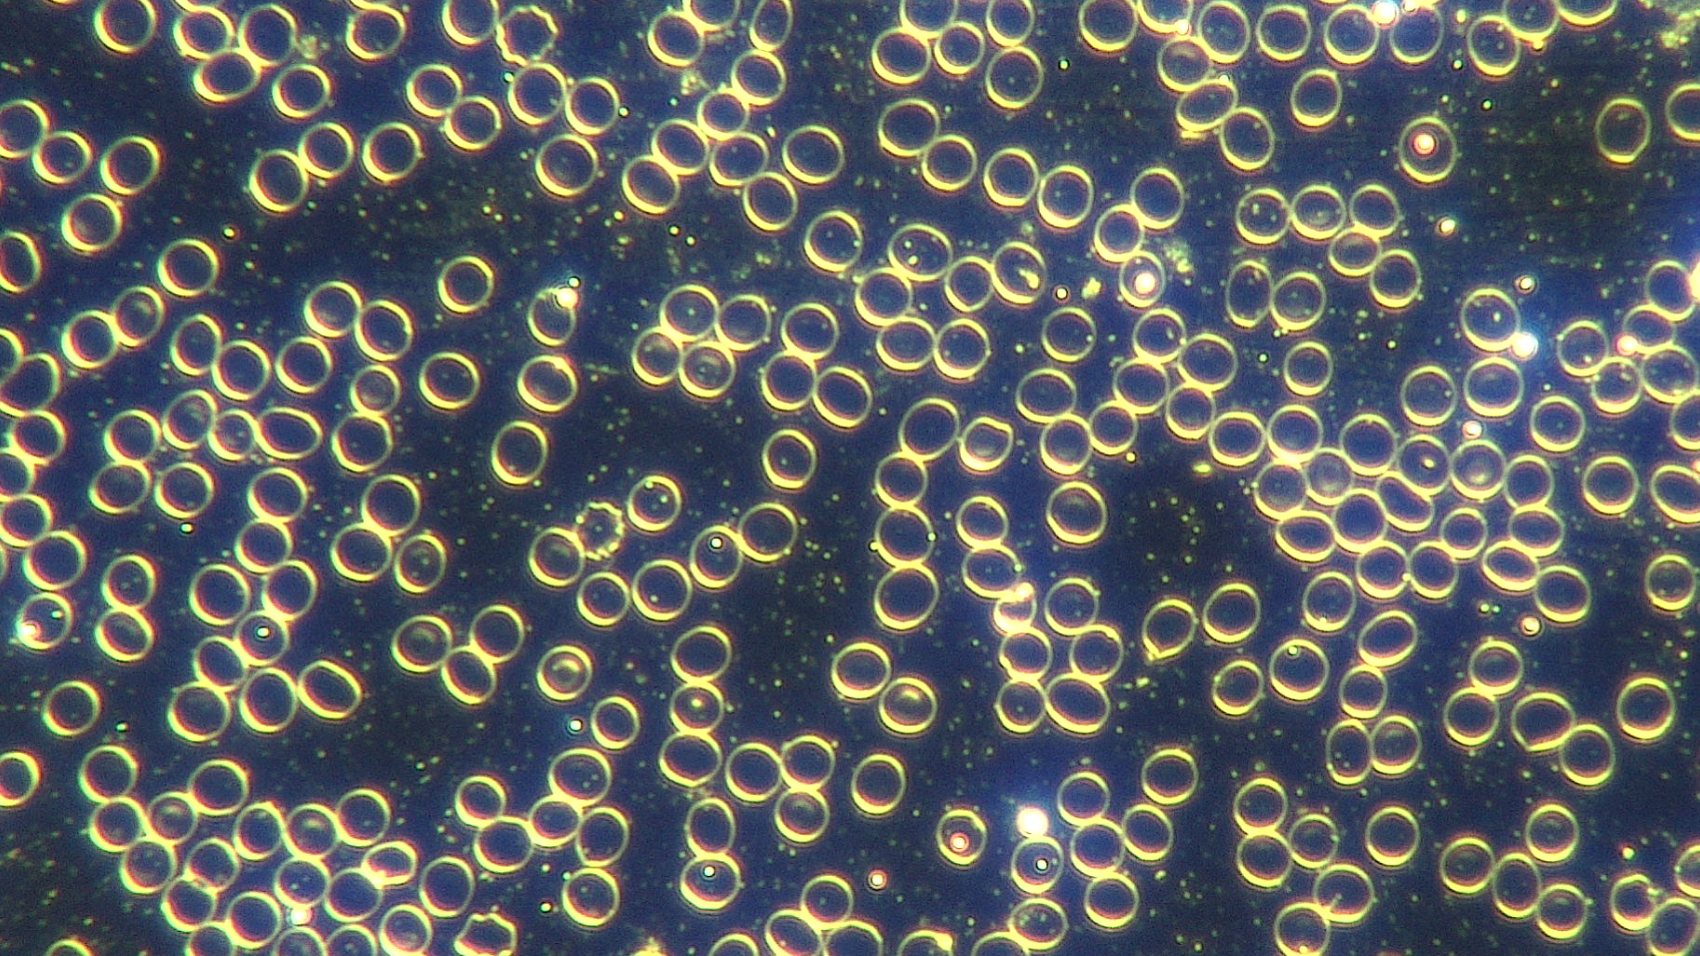

deformed sperm
Free video girls getting fucked hard
Gloryhole Porn Stories
Arab Fuck
A little ugly latin legal age teenager in sex web camera show
MyBestFetish: White booty and spandex fetish
Elizabeth Olsen Ass
Sexy slut Mira rubs her wet shaved pussy
Sophie lynx scene 1hoh
Intercack Porn Foto Full Hd
Gothic Orgy Gothic Orgy Porn Amateur Goth Orgy Amateur Goth Orgy Porn Amateur Goth
Gagged Anal
Download Visual Novel Games For Pc
Tram Pararam Iron Giant
Chelation treatments deformed sperm 114 photos